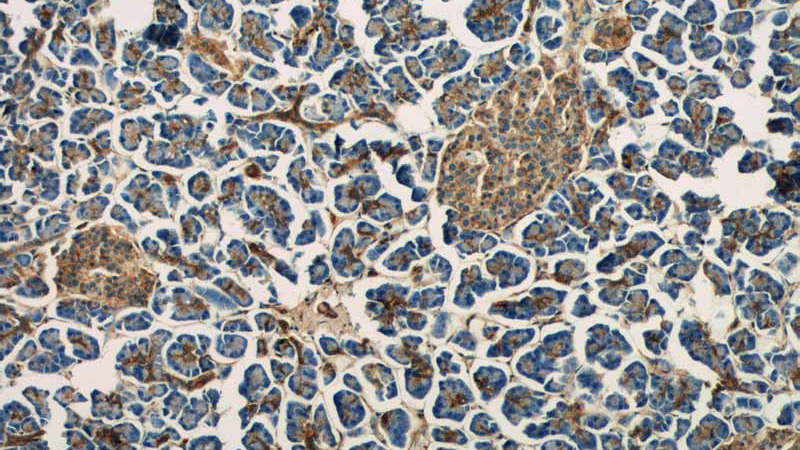
Immunohistochemistry of paraffin-embedded human pancreas tissue slide using Catalog No:108098(ANXA7 Antibody) at dilution of 1:50 (under 10x lens)
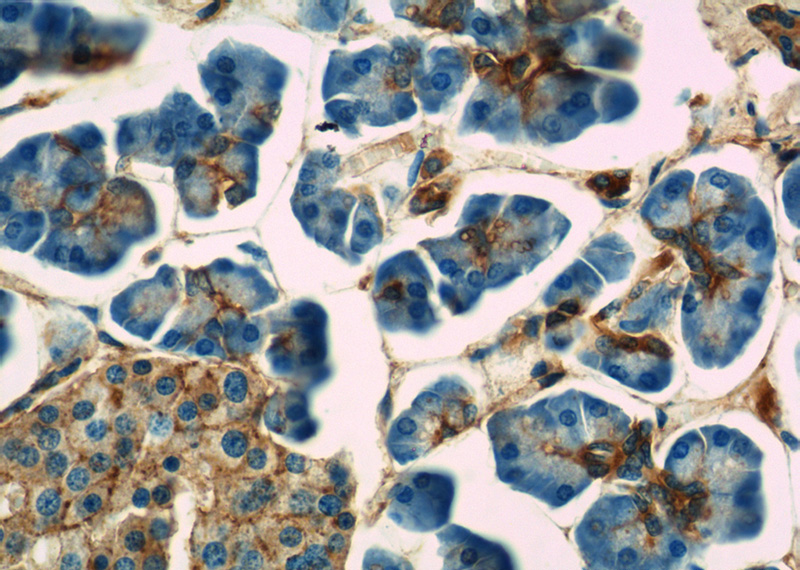
Immunohistochemistry of paraffin-embedded human pancreas tissue slide using Catalog No:108098(ANXA7 Antibody) at dilution of 1:50 (under 40x lens)

-
Product Name
Annexin VII antibody
- Documents
-
Description
Annexin VII Rabbit Polyclonal antibody. Positive IP detected in mouse heart tissue. Positive WB detected in mouse heart tissue, Jurkat cells, L02 cells, mouse brain tissue, mouse lung tissue. Positive IHC detected in human pancreas tissue, human colon cancer tissue, human heart tissue. Observed molecular weight by Western-blot: 47 kDa,51 kDa
-
Tested applications
ELISA, WB, IHC, IP
-
Species reactivity
Human, Mouse; other species not tested.
-
Alternative names
Annexin 7 antibody; annexin A7 antibody; Annexin VII antibody; ANX7 antibody; ANXA7 antibody; SNX antibody; SYNEXIN antibody
-
Isotype
Rabbit IgG
-
Preparation
This antibody was obtained by immunization of Annexin VII recombinant protein (Accession Number: XM_017016163). Purification method: Antigen affinity purified.
-
Clonality
Polyclonal
-
Formulation
PBS with 0.1% sodium azide and 50% glycerol pH 7.3.
-
Storage instructions
Store at -20℃. DO NOT ALIQUOT
-
Applications
Recommended Dilution:
WB: 1:200-1:2000
IP: 1:200-1:2000
IHC: 1:20-1:200
-
Validations

mouse heart tissue were subjected to SDS PAGE followed by western blot with Catalog No:108098(ANXA7 antibody) at dilution of 1:1000

IP Result of anti-ANXA7 (IP:Catalog No:108098, 4ug; Detection:Catalog No:108098 1:800) with mouse heart tissue lysate 3200ug.
Immunohistochemistry of paraffin-embedded human pancreas tissue slide using Catalog No:108098(ANXA7 Antibody) at dilution of 1:50 (under 10x lens)
Immunohistochemistry of paraffin-embedded human pancreas tissue slide using Catalog No:108098(ANXA7 Antibody) at dilution of 1:50 (under 40x lens)
-
Background
Annexin A7 (Anx7) belongs to a ubiquitous and relatively abundant family of Ca2+-dependent membrane-binding proteins, which are thought to be involved in multiple aspects of cell biology including membrane trafficking, mediation of cell-matrix interactions and membrane organization within cells. Anx7, migrated as a 50 kDa protein in SDS-PAGE, has been proposed to function in the fusion of vesicles, acting as a Ca++ channel and as Ca++ -activated GTPase, thus inducing Ca++ /GTP-dependent secretory events.
-
References
- Eisenhofer G, Huynh TT, Elkahloun A. Differential expression of the regulated catecholamine secretory pathway in different hereditary forms of pheochromocytoma. American journal of physiology. Endocrinology and metabolism. 295(5):E1223-33. 2008.
- Yuan HF, Li Y, Zhao Q, Fan LQ, Tan BB, Ye WH. Expression of annexin A7 and its clinical significance in differentiation and metastasis of gastric carcinoma. International journal of clinical and experimental pathology. 7(10):6567-74. 2014.
Related Products / Services
Please note: All products are "FOR RESEARCH USE ONLY AND ARE NOT INTENDED FOR DIAGNOSTIC OR THERAPEUTIC USE"
